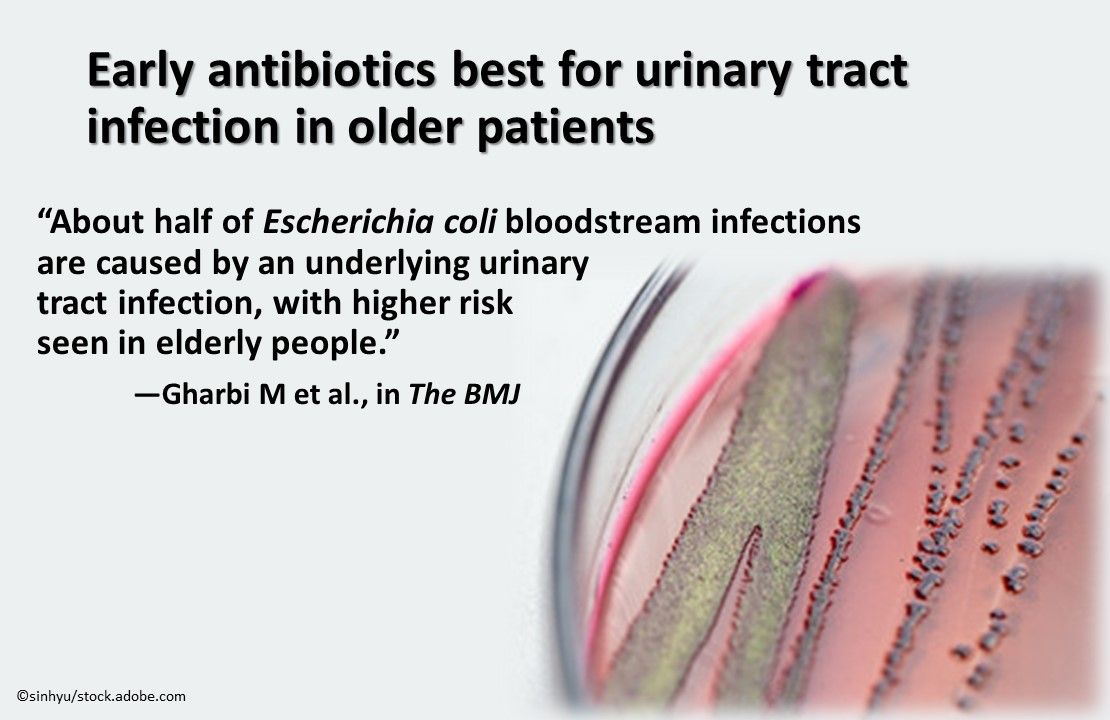
slideshow image

© 2025 MJH Life Sciences™ , Patient Care Online – Primary Care News and Clinical Resources. All rights reserved.
Opioids and infectious diseases, PrEP and STI risk, new oral Rx for C diff, and a shortage of ID specialists. We summarize studies, commentaries, and reports on these topics and more.

While antibiotic-resistant microbes kill hundreds of thousands of persons every year, there is a shortage of infectious diseases specialists, said Matthew McCarthy, MD, in a New York Times opinion piece. He noted that residency programs that fill all their adult infectious disease training positions decreased by >40% from 2009 to 2017 and at many medical centers a board-certified internist accepts a 30%-40% pay cut to become an infectious disease specialist.

Infectious disease medicine is complicated because patients with infectious diseases are complex and a recent study in JAMA offers evidence. Ranking of physician types according to the complexity of patients they see across 9 markers revealed substantial differences. Infectious disease specialists ranked at the top and general internists and family physicians at the bottom--findings that could have implications for medical education and health policy.

A surge in HIV/AIDS, hepatitis, heart infections, skin and soft tissue infections, and other infectious diseases was cited as a byproduct of the ongoing opioid epidemic in a recent Journal of Infectious Diseaescommentary. The authors called for a comprehensive strategy that tailors prevention and treatment approaches to infectious disease in those who abuse or are addicted to opiods and that focuses on opioid use disorder, the underlying predisposing factor.

Injection drug users are often denied treatment for hepatitis C (HCV), even if they are receiving opioid agonist treatment (OAT). A first-of-its-kind study that evaluated models of care that promote adherence to direct-acting-antiviral (DAA) therapy in this population found that all programs that delivered DAA therapy onsite in OAT settings resulted in high sustained virologic response in spite ongoing drug use. Adherence was greater with directly observed therapy than with self-administered individual treatment.

In a Canadian study of unexpected deaths, 6% resulted from infectious diseases. The most common infectious syndromes: bacterial pneumonia (43%), disseminated infection with no clear focus (12%), peritonitis (10%), myocarditis (6%), and pyelonephritis (5%). The most common pathogens: Staphylococcus aureus, Streptococcus pneumoniae, Streptococcus pyogenes, Klebsiella spp., and Escherichia coli. Prodromal symptoms were present in 68% of persons before death. (Image: Klebsiella pneumoniae)

Researchers exploring the risk of bacterial sexually transmitted infections (STIs) in gay and bisexual men after initiation of HIV preexposure prophylaxis (PrEP), focused on incidence of chlamydia, gonorrhea, or syphilis. From preenrollment to follow-up, STI incidence increased from 69.5 to 98.4 per 100 person-years. After adjusting for testing frequency, the increase was significant for any STI and for chlamydia. Frequent STI testing for gay and bisexual men using PrEP was recommended.
In older patients with a diagnosis of urinary tract infection (UTI) in primary care, a study recently published in the BMJ found that no antibiotics and antibiotics prescribed at a follow-up vs the initial office visit were associated with a significant increase in bloodstream infection and all-cause mortality compared with immediate antibiotics. The findings suggest early initiation of antibiotics for UTI in older high-risk adult populations to prevent serious complications. (Image: Escherichia coli )

Oral ribaxamase reduced the incidence of Clostridium difficile infections vs placebo in patients treated with intravenous ceftriaxone for lower respiratory tract infections. Study authors noted that ribaxamase has the potential to prevent C difficile infection in patients treated with IV β-lactam antibiotics. Disruption of the gut microbiome via biliary excretion into the GI tract is thought to be a reason for the high risk of C difficile infection associated with β-lactam antibiotics.

To offer the best protection against the influenza virus, the American Academy of Pediatrics (AAP) will advise families to vaccinate their children with either the flu shot or the nasal spray vaccine. Last year, the AAP cited a preference for the injected vaccine over the nasal spray, except in cases where a child refused the shot. The nasal spray, quadrivalent live attenuated influenza vaccine (LAIV4), is given to healthy patients aged 2 to 49 years.
Antibiotic resistance on the rise with infectious disease specialists in short supply, complicated medicine with complex patients, opioid epidemic begets infectious disease crisis-fresh new perspectives on these and other patient care issues and practices are being presented in recent reports and commentaries in leading journals. Click through the slides below for summaries of the ones that may affect primary care practice.
Related Content: